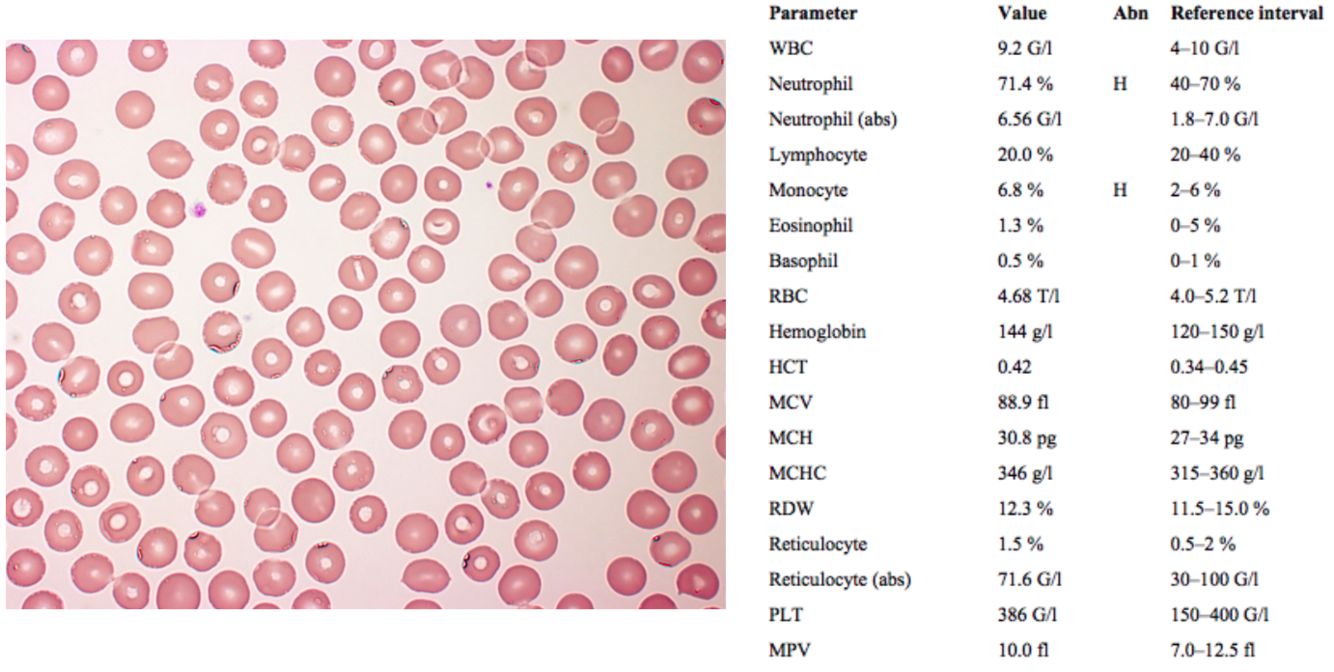
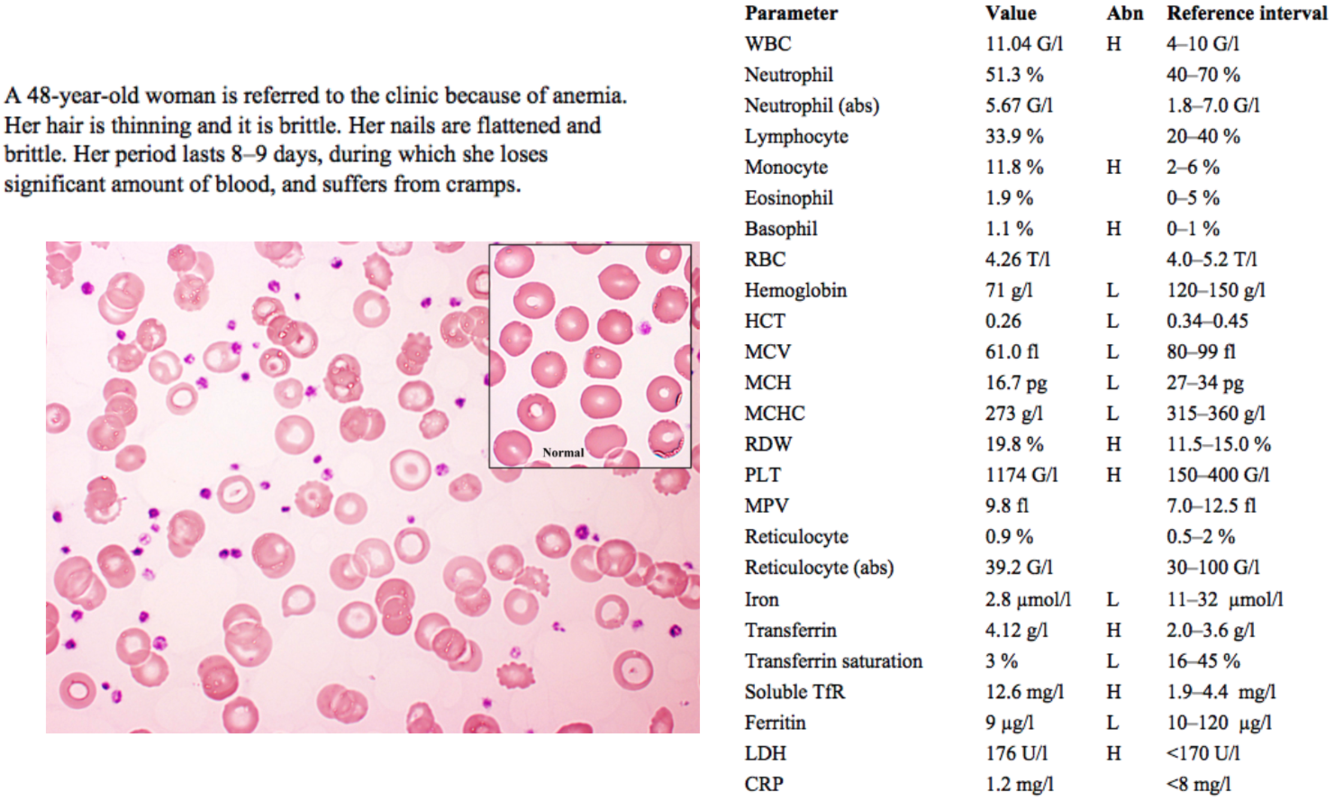
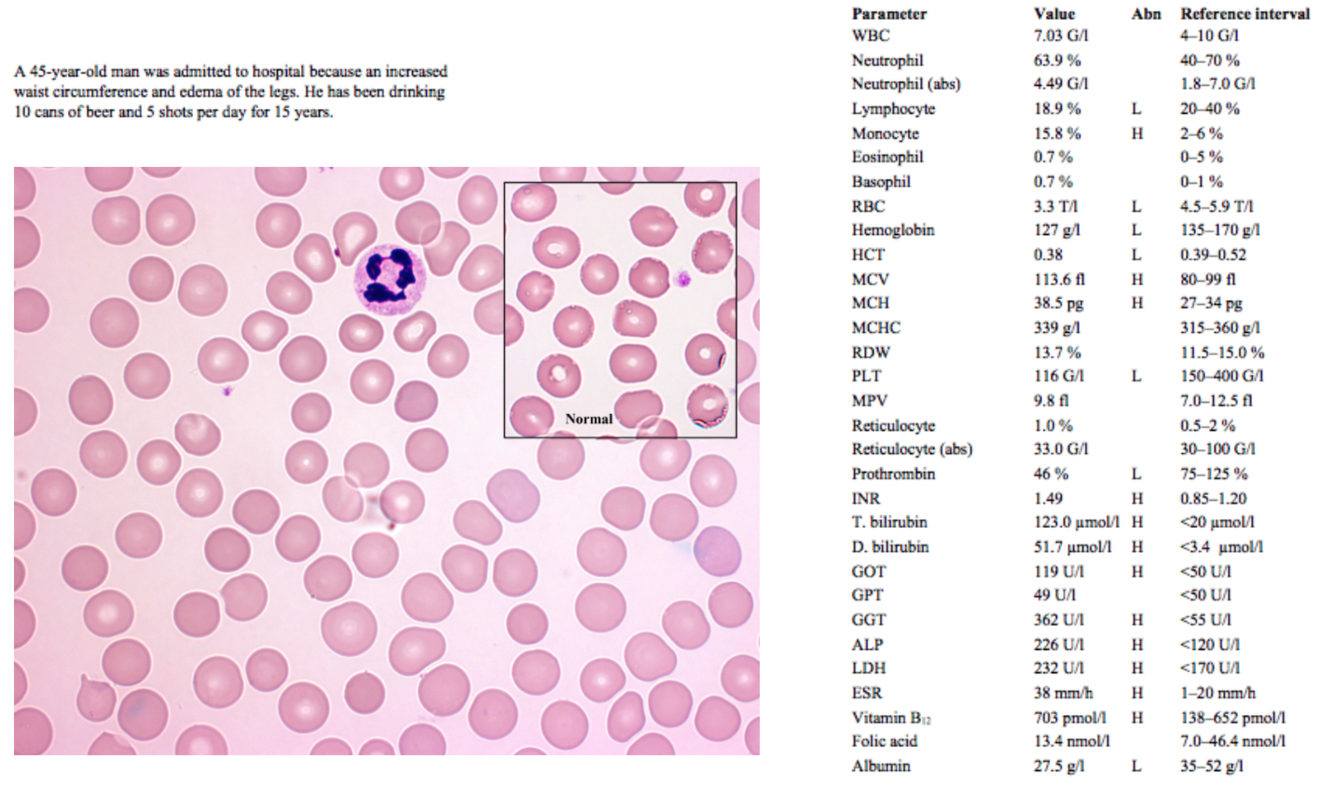
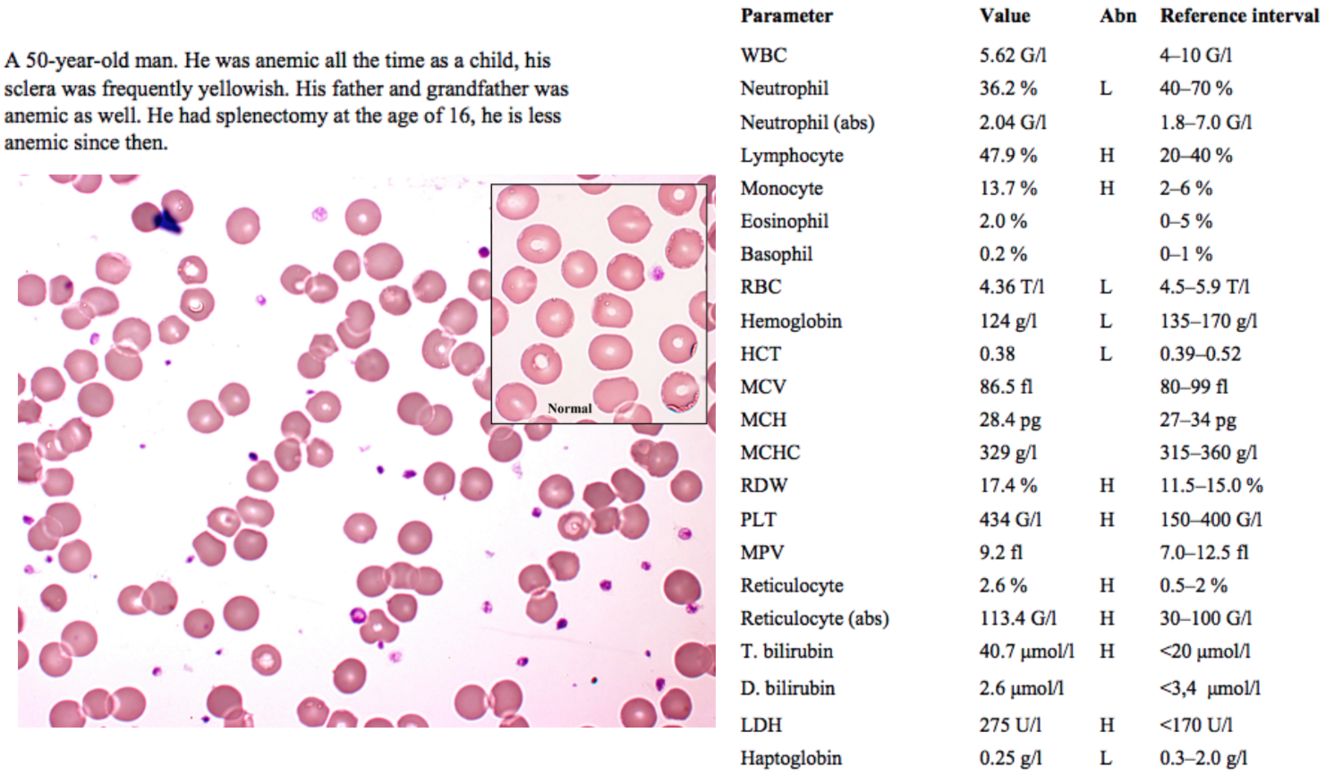

A 41-year-old woman who showed up for a medical screening. She has no complaints.
A 48-year-old woman is referred to the clinic because of anemia. Her hair is thinning and it is brittle. Her nails are flattened and brittle. Her period lasts 8–9 days, during which she loses significant amount of blood, and suffers from cramps.
thin, brittle hair and thin, flattened nails (koilonychia) are signs of iron deficiency anemia
an abnormally long / heavy menstrual period (menorrhagia) associated with significant cramping / pain (dysmenorrhea), and the resultant blood loss, is a common cause of iron deficiency anemia in pre-menopausal women
WBC and monocyte levels are slightly elevated, but not significantly
RBC count is normal, but hemoglobin and hematocrit are low, indicating some form of anemia
MCV, MCH and MCHC are all low indicating microcytic hypochromic anemia
RDW is high (anisocytosis, RBCs of highly variable size)
In the image, abnormally shaped RBCs can be seen (poikilocytosis) with some ring-shaped cells (anulocytosis) and target cells (central hemoglobin concentration surrounded by pale ring, with peripheral band of hemoglobin); all of these are signs seen in iron deficiency
Platelets (PLT) are high, due to a compensatory ↑ renal release of EPO
Iron is low; transferrin is high and transferrin saturation is low (because there is less iron available to bind it), indicating iron deficiency anemia (IDA)
Soluble TfR is high, also indicating IDA
LDH is high, but only slightly. This is insignificant.
The patient should be referred to an OB/GYN for endocrinological + other testing related to her menorrhagia and dysmenorrhea.
Iron supplementation and possibly blood transfusion should be performed to treat the iron deficiency.
A 77-year-old woman was admitted to the hospital due to having a temperature (occasionally fever) for many months, weight loss and bad headaches on both sides in the frontal area.

An elderly patient with chronic fever and weight loss raises suspicion of malignancy
Headaches can be caused by anemia when cerebral vessels dilate to compensate for cerebral hypoxia
Monocytes are slightly, but not significantly, high. This may be due to the inflammation indicated by other parameters below.
Low RBCs, hemoglobin and hematocrit all indicate some form of anemia
MCV is normal (“normocytic anemia”)
MCHC is low, but only slightly, so fewer cells are visibly hypochromic than in the previous case
Platelets are high probably as a result of ↑ EPO in reaction to anemia.
Iron is normal; transferrin is low, transferrin saturation is high, and ferritin is high.
Increased LDH in this case can be due to malignancy or hemolytic anemia (possibly autoimmune), both of which can be related to ACD. Otherwise, LDH may indicate heart attack, stroke, liver disease, etc.
High CRP and ESR both indicate inflammation, further supporting a diagnosis of ACD.
Diagnostic testing (i.e. serum tumor markers, imaging, autoantibodies, specimens for culture / PCR etc.) should be performed in order to diagnose and treat the underlying chronic disease
Parenteral iron can be administered if infection is not suspected / ruled out
A 45-year-old man was admitted to hospital because an increased waist circumference and edema of the legs. He has been drinking 10 cans of beer and 5 shots per day for 15 years.
Increased waist circumference could be simply an increase in central adipose tissue, but accompanied by edema and long-term excessive alcohol intake is more likely to be hepatomegaly or ascites due to liver damage
Lymphocytes are slightly low, but since the value is a percentage this may just be due to the excess of monocytes
Monocytes are significantly elevated, which is common in acute alcoholic hepatitis.
RBCs, hematocrit and hemoglobin are low, indicating some form of anemia
MCV is high, indicating a macrocytic anemia
MCH is high, which is normal in case of macrocytic anemias, since each individual RBC is larger and MCH is an absolute value, not a concentration (MCHC is normal)
Causes of macrocytic anemias are:
Platelets are low; in the case of long-term alcoholism, cirrhosis and portal hypertension can develop, causing hypersplenism with retention + destruction of WBCs and/or platelets in the spleen
Prothrombin is low and INR is high due to impaired production of clotting factors in the damaged liver
Total bilirubin and direct bilirubin are high, and indirect bilirubin is also high when calculated from these two values.
This hyperbilirubinemia is due to liver damage and hemolysis???
GOT (ASAT) is high, but GPT (ALAT) is not → a disproportionate increase in ASAT more than ALAT is characteristic of alcoholic liver damage (if ALAT > ASAT, viral hepatitis is more likely); GGT and ALP are also high, further indicating liver damage
LDH is high due to liver damage and some hemolysis of the macrocytic RBCs in the spleen and capillaries.
ESR is high, probably due to the inflammation induced by liver damage
Albumin is low because of impaired production in the liver
Vitamin B12 is slightly high and folic acid is normal, ruling out 2 deficiencies which commonly cause macrocytic (specifically “megaloblastic”) anemias.
Folic acid deficiency is especially common in alcoholics, due to decreased intestinal absorption
The patient’s liver should be examined thoroughly (US, etc.) to determine the extent of damage (steatosis < hepatitis < cirrhosis) and the patient should be instructed to stop drinking and offered treatment options such as counseling, inpatient rehab, etc.
A 50-year-old man. He was anemic all the time as a child, his sclera was frequently yellowish. His father and grandfather was anemic as well. He had splenectomy at the age of 16, he is less anemic since then.
An old man who has been anemic since childhood, along with two relatives with the same condition, indicates a hereditary cause.
Frequently yellow sclera indicates a hemolytic cause of the anemia.
Improvement of anemia after splenectomy also indicates a hemolytic cause, as the spleen is frequently involved in RBC destruction in hemolytic anemias
WBC count abnormalities are not significant.
Slightly low RBC, hemoglobin and hematocrit all point to some form of anemia.
Normal MCV and MCHC indicate a normocytic normochromic anemia, which is seen in hemolytic anemias.
Increased RDW is seen when the bone marrow is quickly producing and releasing variably sized erythrocytes and reticulocytes to compensate for anemia.
Increased platelets are seen due to ↑ EPO release from the kidney
Reticulocytosis is another common feature of hemolytic anemias, indicating that underproduction is not the issue and the bone marrow is compensating well for the hemolysis
nonconjugated hyperbilirubinemia (high T. bilirubin with normal D. bilirubin) occurs in cases of hemolysis, as does release of LDH.
Haptoglobin, a serum protein that binds free hemoglobin to reduce its toxicity / oxidative activity, is decreased in hemolysis due to the hemoglobin release from lysed RBCs.
The slide image shows some RBCs with less “central pallor” (paleness) than usual, indicating a rounder, less biconcave shape.
Based on all of this information, this is likely hereditary spherocytosis
An 18-year-old woman has been admitted to the ED. She has been complaining of a very intense abdminal pain and weakness for a day. She is a refugee who arrived two weeks ago from a Sub-Saharan country.

A recent immigrant from sub-Saharan Africa presenting to the emergency department with abdominal pain and weakness seems like a possible parasitic infection at first
The slide shows numerous sickle-shaped cells, and sickle cell anemia is more common among people of African descent
Again, high WBCs might indicate infection, but none of the counts are extremely high
Significantly decreased RBCs, hemoglobin and hematocrit indicate some form of anemia.
RDW is highly increased (“anisocytosis”) which is common in sickle cell anemia, since so many of the RBCs are abnormally shaped
High reticulocytes indicate that this is not a problem of production, and that the bone marrow is trying to compensate for the anemia.
Total bilirubin is high, most of which is indirect bilirubin; as mentioned before, indirect hyperbilirubinemia is normal in cases of hemolysis, as is increased LDH
Again haptoglobin is low because Hgb released from the lysed RBCs is binding it
The direct Coombs test looks for the presence of IgG auto-antibodies bound to the patient’s RBCs in immune-mediated hemolysis:
Sickle cell disease occurs when at least one of the β-globin subunits of hemoglobin A is mutated, forming so-called hemoglobin S
A middle aged man complains of reduced tolerance of physical activity and effort dyspnea. His general appearance, however, is fine. His hair and beard are white, throughout his body he has hypopigmented areas. He noticed to develop hypopigmentated areas 30 years ago, which got larger and more numerous.
His tongue is smooth, shiny and sensitive.

A middle-aged man with reduced activity tolerance and effort dyspnea; these symptoms are not specific, but can be related to anemia.
White hair and beard of course can be normal for a middle-aged man. Skin pigmentation issues can be related to B12 deficiency, but these usually present hyperpigmentation.
The hypopigmentation here is a sign of vitiligo, a condition of hypopigmentation (possibly due to an autoimmune reaction against tyrosinase, an important enzyme in the synthesis of melanin). Vitiligo is often associated with other autoimmune diseases, such as Hashimoto’s thyroiditis, RA, SLE and pernicious anemia.
A smooth, sensitive tongue is also common to B12 deficiency. In B12 deficiency the tongue is also often described as “red and beefy”. Yum.
Significant decreases in RBCs, Hgb and Hct indicate some form of anemia
High MCV indicates a macrocytic anemia; although MCH is high, MCHC is normal, so this is a macrocytic normochromic anemia.
Low platelets are also due to B12 deficiency, and the resulting dysfunctional thrombopoiesis
Low monocytes could also be due to the B12 deficiency, but are not significantly low here.
RDW is high, which occurs when RBC production / maturation is altered by B12 deficiency
Reticulocytes are low, suggesting an anemia which is not well compensated by increased erythropoiesis
Iron levels are high, due to the excess iron released as macrocytic RBCs are lysed in the smaller vessels and spleen
Transferrin saturation is high because the excess free iron binds transferrin in the blood
Ferritin levels are also high, since as more iron is released from hemolysis and less is incorporated into Hgb in new RBCs, more is store.
Vitamin B12 is low, confirming earlier signs that this was an anemia due to B12 deficiency.
Total bilirubin is high, most of which is indirect, which is consistent with the hemolysis seen in macrocytic anemias. The high LDH is also likely just due to hemolysis, but a more isozyme-specific LDH test would need to be done to rule out other tissue damage as a source of increased LDH.
Low haptoglobin is present because as more Hgb is released from lysed RBCs, haptoglobin binds it.
The negative direct Coombs test rules out an autoimmune hemolytic anemia.
With the B12 deficiency and signs of autoimmunity, this is most likely pernicious anemia (PA).
For further confirmation that this is PA, and not a B12 deficiency of some other etiology, serum tests for anti-IF and anti-parietal cell Abs can be done.
Treatment of PA involves vitamin B12 supplementation; since IF is lacking, oral supplementation must be with high doses, and often subcutaneous injections are given instead.
A middle aged woman. She has been feeling weaker and more tired for two weeks. Her family doctor performed some lab test. and referred her to the hospital based on the results.

Fatigue and weakness with significantly elevated WBCs (specifically neutrophils) are non-specific signs and could be indicative of infection or a hematological neoplasm.
Notice that the differential values for other types of leukocytes are missing. This is because when a high number of abnormal cells are found in the periphery, automatic WBC counts are thrown off.
Anemia and thrombocytopenia are seen (low RBC, Hgb, Hct and platelets). These are common signs of hematological neoplasms, as overproduction of WBCs “crowds out” erythrocyte precursors and megakaryocytes from the bone marrow.
High uric acid and LDH are present due to the high cellular turnover (and thus altered purine metabolism) seen in hematological disorders.
Peripheral cytometry shows 52% blasts. This meets the acute leukemia criteria of >20% blasts in either periphery or marrow.
Bone marrow microscopy shows characteristic signs of an acute leukemia: hypercellularity, increased blasts (larger 15-20 um cells with large nuclei, narrow basophilic cytoplasm, loose chromatin).
The peripheral blood smear picture shows the presence of several blast cells. At the top of the image there is one band cell, and to the far right one lymphocyte.
Flow cytometry of marrow shows basically the same CD expression as FCT of peripheral blood.
Cytogenetics and FISH show a translocation of 11q23 to the X chromosome, a relatively rare but known genetic cause of AML in adults.
(It’s also good to know the general WHO classification for AML found on slide 32 of the department’s acute leukemia slides. Some students were asked this on the midterm.)
A 72 year-old-man lost 5 kg of body weight in 2 months. He complains of having a temperature and sweating. He looks pale. There is no lympadenopathy, however, his spleen is 8 cm below the ribs.

An old patient with a recent significant weight loss, temperature and sweating immediately raises suspicion of malignancy.
Paleness is a sign of anemia, which is confirmed by the blood count results.
Splenomegaly is a common sign of hematological malignancy.
(The old notes for this question said that basophilia, thrombocytosis and splenomegaly were a “classic” clinical triad for CML. This case does not mention a basophil count or high platelets, but this is useful information anyways.)
An extremely high leukocyte count (~16x upper limit) also points to a possible hematological malignancy.
As with the previous case, an increase in proliferation of leukocytes has “crowded out” erythropoietic precursors from the bone marrow, resulting in anemia.
Low prothrombin and high INR indicate an issue with production of clotting factors in the liver, possibly due to hepatic infiltration by the surplus of peripheral leukocytes.
High serum uric acid is again due to the increased cellular turnover seen in diseases of excessive leukocyte proliferation.
Increased ALP and LDH also indicate hepatic damage and increased cellular turnover.
Bone biopsy shows hypercellularity with an increased myeloid:erythroid ratio, both of which are seen in myeloid leukemias (Normal M:E ratio is ~2:1, but in CML is 10-30:1).
Most cells in the marrow are fully differentiating granulocytes, with an increased number of “intermediate hypogranular cells”. This corresponds to the _pro_myelocyte-myelocyte-metamyelocyte stages of granulocyte maturation, which are the cells found in high numbers in CML.
Cytogenetics reveal the presence of the Philadelphia chromosome, a reciprocal translocation of the of the ABL1 gene on chromosome 9 to the site of the BCR gene on chromosome 22, indicated as t(9;22). This translocation results in a fusion gene that is encodes for an unregulated tyrosine kinase enzyme, causing unregulated cell division. This mutation is typical of cases of chronic myeloid leukemia.
CML consists of 3 phases: (for more info see slides 26-36 of the practical presentation)
Treatment of CML is with imatinib (brand name Gleevec), a tyrosine kinase inhibitor.
As neoplastic cells die during treatment, uric acid can further increase, causing gout and tumor lysis syndrome. This can be avoided by co-treatment with allopurinol, to decrease uric acid levels.
An 85-year-old woman has been treated with several antibiotics due to a respiratory infection for the last few weeks. She is having a diarrhea as well, that is getting gradually worse and worse. She has watery, greenish and mucous stools. At the time of admission she in a severe condition due to her fever, abdominal pain and meteorism. Clostridium difficile antigen and toxin are positive in her fecal sample.

All the clinical information points towards Clostridium difficile infection and the stool toxin and antigen tests confirm this.
High WBCs, specifically with high neutrophils, are a sign of bacterial infection, but may also indicate hematological malignancy.
The blood smear image shows some granulocytes of unusual morphology. In bacterial infections, reactive increases in WBC production can lead to the release of granulocyte precursors into peripheral blood.
The main point of this question is to differentiate between a leukemoid reaction (normal increase in WBCs seen in infection, aka reactive leukocytosis) and leukemia. Several other things can indicate a leukemoid reaction:
CRP is an acute phase protein, and its elevation indicates acute inflammation.
Procalcitonin is an acute phase protein that is specific to bacterial infection; it does not rise in the case of viral or non-infectious inflammation.
A 56-year-old woman is referred to the hospital by the family doctor due to having “too thick blood”. She is a heavy smoker. She has a plethoric complexion and acrocyanosis. Her spleen is 6 cm below the ribs. SatO2: 95%

Not sure why the family doctor is using terms like “too thick blood”, but already this points towards high hematocrit, which is known as polycythemia. This is verified by the RBC, Hgb and HCT counts.
Heavy smokers such as this woman have an increased risk of developing COPD, which may lead to hypoxia, a reactive increase in erythropoiesis and thus polycythemia.
A “plethoric” complexion just means redness, as if the dermal vessels are congested. Acrocyanosis (cyanosis of the hands/feet) is a sign of poor circulation or hypoxemia.
Oxygen saturation is normal, ruling out a pulmonary cause of the cyanosis.
Splenomegaly indicates a possible myeloproliferative disorder.
WBCs are high, specifically neutrophils, with relatively lower lymphocytes and monocytes
High reticulocytes and platelets further indicate some kind of excessive myeloproliferation. Since many myeloproliferative disorders (CML, AML, etc.) involve anemia, and contrary to that this case presents with increased RBCs and hematocrit, it is likely polycythemia vera (PV).
Increased LDH is due to hemolysis, as excess RBCs are destroyed in the spleen.
Increased uric acid is due to the increased cellular turnover seen in all myeloproliferative disorders.
Treatment is via phlebotomy, but even with treatment median survival is only about 10 years, due to vascular complications. Patients may eventually enter a “spent” phase in which their bone marrow resembles that of patients with myelofibrosis.
A 69-year-old woman has been monitored at out hematologic ambulance for 3 years because of an accidentally discovered, abnormal CBC result. She has a negative cardiovascular anamnesis. She takes 100 mg aspirin daily.

Not sure if there is any significance to the cardiovascular anamnesis other than that her high platelets have not caused any thrombosis. ASK ABOUT THIS
She is likely taking the aspirin to prevent thrombus formation
Monocyte and RDW elevation are not significant.
An extreme elevation in platelets indicates possible essential thrombocythemia (ET), a rare neoplastic proliferation of megakaryocytes
LDH increase is not severe, but may be due to thrombus formation resulting in occlusion and mechanical hemolysis.
Diagnostic criteria for ET include:
Treatment for ET is plasmapheresis to remove platelets from circulation; sometimes low-dose chemotherapy is used.
A 19-year-old young man who has had a sore throat and a fever for a week. The is greyishwhite coating on the swollen tonsils. There is lymphadenopathy on the neck. Spleen is palpable.

A young patient with a sore throat and fever is probably indicative of some form of upper respiratory infection.
An exudative tonsillitis points toward the possibility of mononucleosis (an infection with either Epstein-Barr virus or cytomegalovirus).
Cervical lymphadenopathy also supports a diagnosis of mononucleosis. An important question is whether the swollen nodes are painful or not; in mononucleosis they would be painful, whereas in other conditions such as lymphoid leukemias they may not.
Splenomegaly can be seen in many hematological disorders. In this case it could indicate either mononucleosis or a leukemia.
WBCs are slightly elevated. Lymphocytosis in the range of 12-18 G/L is typical of mononucleosis, although not specific.
Notice that the WBC differential values are missing. This is due to the presence of a high number of abnormal cells in the periphery. Microscopy of a peripheral blood smear would be helpful in the diagnosis of this case:
Bilirubin and liver enzyme elevation is indicative of liver damage. Liver damage with hepatomegaly is a common sign seen in both infectious mononucleosis and leukemias.
High LDH is also indicative of some kind of cellular damage, probably the liver damage already noted.
For some reason the high CRP is not denoted with an “H”… CRP indicates inflammation and can be elevated in both mononucleosis and CLL.
The diagnostic criteria for infectious mononucleosis are:
Another test for EBV-related infectious mononucleosis is the monospot test, AKA heterophile antibody test.
A 77-year-old man who has been monitored in the hematological ambulance since 2009. There is no palpable lymphadenopathy or splenomegaly.
There are no general symptoms like weight loss, sweating or fever.
There is no increased susceptability for infections. Drug therapy was not required for him yet.

The patient’s age and the fact that he has been monitored regularly by a hematology department suggests that it’s probably a chronic hematological problem
A very mild anemia is present. This may be insignificant, due to the patient’s age, but in the presence of leukocytosis is suggestive of a possible hematological malignancy.
Thrombocytopenia also supports the possibility of hematological malignancy. Both anemia and thrombocytopenia are seen in CLL.
The peripheral cytometry gives us the clearest picture of this patient’s condition and confirms previous suspicions:
This patient has low CD38 expression, and thus his leukemia has progressed more slowly and with fewer noticeable symptoms.
(Molnar apparently really likes this part and gave someone a much worse grade for not knowing this)
A peripheral lymphocyte count and smear would also help to confirm the diagnosis:
Therapy is not indicated in asymptomatic CLL patients, but the patient should continue to be monitored regularly.
A 59-year-old man complains of being very weak and having significant pain in the lower back. He had a long lasting pneumonia two months ago.
*according to the internet eGFR should be above 90 not 60, then 81.5 being low makes sense

A 59 year old man complaining of weakness and lower back pain:
WBC count is normal, ruling out leukemias such as CLL, CML, and AML. ALL presents with variable leukocyte counts, and plasma cell disorders do not generally present with leukocytosis.
Anemia is present, and is common to many hematological disorders.
ESR is high, indicating inflammation. CRP is normal, however.
eGFR is slightly low and BUN is slightly high. This may indicate renal dysfunction. However, neither is significantly outside of its reference range and this may just be due to the patients old age, as GFR normally decreases with age.
High serum uric acid indicates a high rate of cellular turnover, further supporting the likelihood of a hematological disorder.
Calcium is slightly low. Normally cases of multiple myeloma present with hypercalcemia, as bone lesions caused by the malignancy release calcium. This paradoxically low calcium may also be due to calcium wasting in the kidney, via similar mechanisms to what caused the sodium loss.
Many of the signs are already discussed are part of the “CRAB” diagnostic criteria for end-organ damage caused by multiple myeloma:
CRAB signs plus two other diagnostic criteria are sufficient to diagnose multiple myeloma:
High serum total protein may indicate the presence of M proteins, and further investigation of serum proteins must be done to verify this.
High β2-microglobulin is often seen in multiple myeloma, and has prognostic significance. Higher levels correlate to lower median survival time.
Serum Immunoglobulins and electrophoresis show the presence of high IgG, with levels of all other immunoglobulins and albumin being low. This is typical of multiple myeloma, as overproduction of a single antibody suppresses production of other serum proteins.
Multiple myeloma therapy consists of: